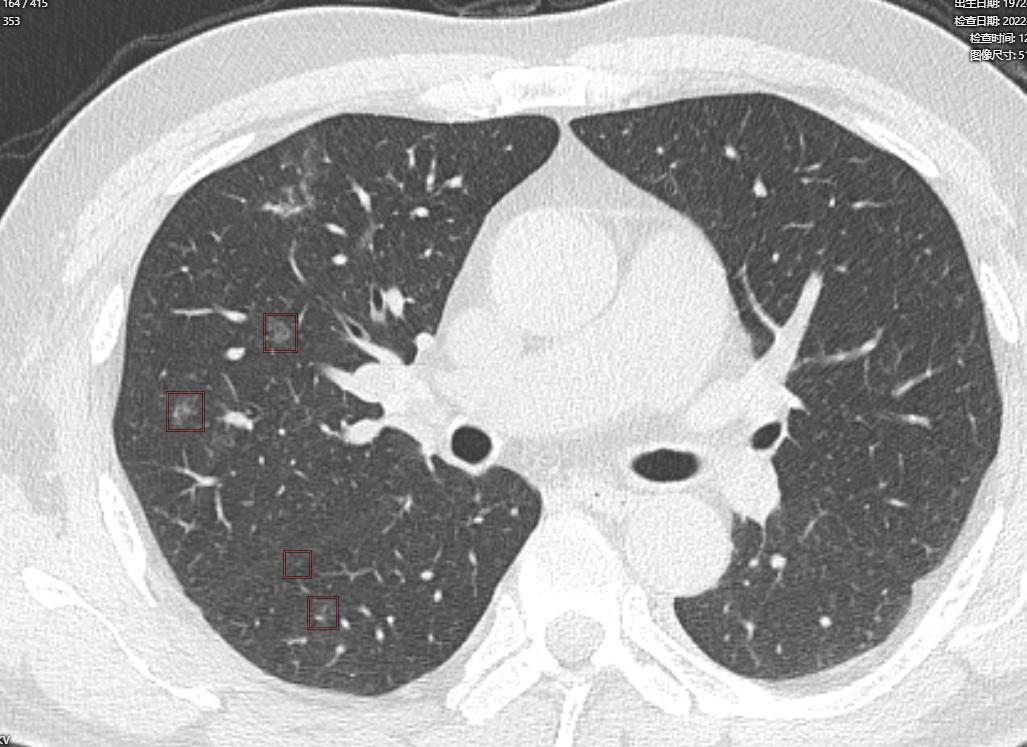
阜阳新冠病毒最新通告,变化带来自信,学习铸就未来之路

阜阳发布新冠病毒最新通告,表明城市在积极应对疫情变化。变化带来信心,表明阜阳在疫情防控方面取得积极进展。同时强调学习的重要性,通过学习来应对未来的挑战。阜阳发布新冠病毒最新通告,积极应对疫情变化,展现自信;同时注重学习,为未来铸就坚实基础。
我们带着希望和坚定的信念,向大家通报新冠病毒的最新情况,这场突如其来的疫情,无疑给我们的日常生活带来了挑战,但请相信,正是这样的时刻,我们更需要团结一心,共同面对,我想和大家分享一个信息,那就是变化带来的自信与成就感,以及如何在这一过程中融入正能量和幽默感。
这场疫情让我们不得不适应远程工作、在线学习等新的生活方式,这些变化虽然带来了诸多不便,但也促使我们学会适应,学会改变,在这个过程中,我们学会了新的技能,掌握了新的知识,这种学习的成就感不仅让我们知识增长,更让我们自信心倍增,我们学会了在逆境中寻找机会,在挑战中找到成长的动力。
学习,正是我们面对困境的最好武器,无论是学习新的技能,还是掌握新的知识,我们都能从中找到自信与力量,当我们掌握了足够的知识,就能更好地理解这个世界,更好地面对生活中的挑战,让我们拥抱变化,享受学习带来的乐趣。
关于阜阳新冠病毒的最新通告,我们正处于挑战之中,但我们有信心、有能力战胜疫情,让我们一起学习、一起进步、一起迎接美好的未来,这个过程并不轻松,需要我们付出努力,需要坚持不懈,但请记住,每一次的努力都不会白费,每一次的坚持都会让我们变得更强大。
让我们带着笑容面对挑战,用幽默感化解压力,在学习的过程中,不妨给自己一些鼓励,比如每掌握一项新技能就给自己一个小小的奖励,这样,我们就能在轻松愉快的氛围中不断进步。
在这场疫情中,团结一心是我们最重要的力量,我们要相信科学的力量,相信医护人员,相信政府,我们也要相信自己的力量,相信自己能够在这场战斗中发挥重要作用。
让我们共同为阜阳加油,为中国的未来加油!在这个特殊的时期,让我们一起努力,勇往直前,只要我们团结一心、勇往直前,我们一定能够战胜疫情,创造更美好的未来!
我想特别对阜阳市民说:你们辛苦了!你们在这场疫情中的付出和努力,是我们战胜疫情的最大动力,让我们一起携手前行,共同创造阜阳的美好未来!

京公网安备11000000000001号
京ICP备11000001号